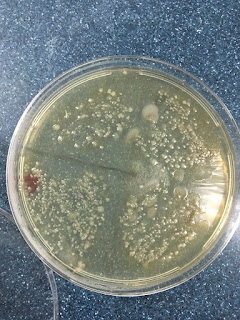

Universidad Latina De Panamá
Facultad De Ciencias De La Salud
Licenciatura en Farmacia
¨Laboratorio Sembrado en placa de microorganismo del medio ambiente¨
III Cuatrimestre
Profesor Ricardo Vizuete
Integrantes:
Alicia Cheung
Katiuska Guan
Mileika Lineth
Ariel Ledezma
Maribel Len
Isabel Luo
Juan Montes
Magda Rodruigez
Nayeli Garcias
Melissa Wan
Yamilka Yau
Diciembre de 2015
Universidad Latina De Panamá
Magda Rodruigez
Diciembre de 2015
SEMBRADO EN PLACA DE
microorganismos del medio ambiente
INTRODUCCIÓN
La población microbiana existente en nuestro
entorno es grande y compleja. Cientos de especies microbianas habitan
normalmente en distintas partes de nuestro cuerpo, incluidas la boca, el tracto
intestinal y la piel. Al nacer, los microbios inmediatamente empiezan a
colonizar nuestros cuerpos, así como a casi todos los objetos del mundo. Ellos
flotan alrededor hasta que entran en contacto con una superficie que ofrezca
comida y resguardo. Se encuentran más frecuentemente en la oscuridad, en
objetos húmedos que a menudo entran en contacto con la comida, la suciedad o la
vegetación. Las superficies del baño, los cepillos para el cabello, los
refrigeradores, los lavaplatos y las tablas de cocina tienen a menudo muchos
microbios. Las manijas y las paredes tienen menos porque son pobres en
nutrientes y secos.
Un estudio adecuado de microorganismos que
hay en estos hábitat requiere técnicas que permitan conocer y ordenar la
compleja población mixta o cultivo mixto, separándole en sus distintas especies
como cultivos puros. Un cultivo puro consta de una población de células
derivadas todas ellas de una célula parental.
Los microorganismos se cultivan
en el laboratorio sobre materiales nutritivos denominados medios. Se dispone de
una gran cantidad de medios y la clase que se debe de utilizar depende de
muchos factores, uno de los cuales es la clase de microorganismos que se va a
cultivar. El material que se inocula sobre el medio se denomina inóculo
mediante alguna técnica (siembra por estría en placa o siembra en masa en
placa).
Durante la incubación a 37:C , las células microbianas individuales se
reproducen tan rápidamente que en un lapso de 18 a 24 horas producen masas
visibles de células denominadas colonias. Una colonia es visible a simple
vista. Cada colonia diferente es
presumiblemente un cultivo puro de una sola clase de microorganismo. Si dos
células microbianas procedentes del inóculo original quedan muy cerca una de
otra sobre el medio de Agar, la masa de células observables no será un cultivo
puro. La mayoría de los microbios en nuestro cuerpo y otras superficies son
inofensivas, pero algunos son patógenos o causan enfermedad. Por esta razón,
queremos controlar el número de microbios que nos rodea. La posibilidad de
infectarnos aumenta con el número de microbios en los objetos circundantes.
Pero ¿qué podemos hacer para reducir el número de microbios en las superficies
que nos rodean?
Objetivos
- Observar la gran variedad de microorganismos presentes en el medio ambiente, determinando las diferentes morfologías de colonias que se obtienen.
- Los efectos de un desinfectante por medio del crecimiento de colonias de bacterias en un medio de cultivo en cajas de Petri.
MATERIAL
- 3 cajas de Petri estériles preparadas con Agar nutritivo
- Caja de hisopos estériles sin abrir toallas de papel
- 3 cajas de petri estériles preparadas con Agar
sangre.
- Cinta pegante
- Marcador permanente o lápiz de cera
- Un desinfectante con 70% de solución de alcohol, 10% de una
solución blanqueadora, jabón líquido Extran o alkox , septisol.
PROCEDIMIENTO
En esta actividad escogerás un fomite
(cualquier objeto inanimado que pueda causar enfermedad en los organismos por
contener microorganismos como: la manija, el marco, el control remoto de la
televisión, una moneda). Este fomite ayudará a confirmar la presencia de
microbios y los efectos de un desinfectante por medio del crecimiento de
colonias de bacterias en un medio de cultivo en cajas de Petri.
1. Si tienes el cabello largo, recógetelo
para mantenerlo lejos de las cajas de Petri cuando estés trabajando. Lava tus
manos. Limpia tú área de trabajo frotando suavemente, con la solución
desinfectante en una toalla de papel. Saca tus cajas de Petri pero no abras las
cajas hasta que se te indique.
2. Escoge un objeto del salón de laboratorio (la manija, el marco, el
control remoto de la televisión, una moneda, etc.). Toma una caja de Petri sin abrir y con tú lápiz de cera o
marcador, divide la base de la caja en cuatro secciones iguales. Escribe el
nombre del objeto al otro lado y designa las secciones de 1 hasta 4. Abre la
caja de hisopos de algodón y escoge uno con cuidado para no tocar la punta.
Limpia tú objeto escogido con todos los lados de la punta del hisopo
volteándolo y retorciendo el hisopo a medida que lo mueves por la superficie
del objeto.
3. Ahora abre la tapa de la caja y suavemente
haz cuatro siembras sobre la superficie de la caja como se muestra en la
ilustración, empezando en la sección designada "1" y continuando en
el orden de las secciones, de manera que la última siembra esté en la sección
4. Presiona firme pero suavemente y no retiñas las siembras anteriores. Tus
siembras sólo deben dejar una impresión muy ligera en el Agar. Cierra la caja y
séllala con dos pedazos de cinta. No cubras la caja con cinta o no podrás verla
bien.
4. Divide una segunda caja de Petri en 4
secciones numeradas de 1 hasta 4 y desígnala “Control.” Limpia la mitad del objeto que escogiste
anteriormente con una toalla de papel humedecida con agua-solo frótala un par de veces; no la restriegues. Con un nuevo hisopo estéril, toma muestra del
área limpiada. Abre la tapa de la segunda caja y haz SUAVEMENTE 4 siembras en
la superficie de la caja, siguiendo el orden de las secciones numeradas como lo
hiciste previamente. Cierra la caja y séllala.
5. Divide la tercera caja de Petri en 4
secciones numeradas y desígnalas con el nombre del desinfectante que escogiste (por ejemplo "blanqueador").
Usa el desinfectante escogido para limpiar la otra mitad del objeto que
trabajaste antes. Con un nuevo hisopo estéril, toma muestra del área. Repite el
proceso de sembrar la caja. Ciérrala y séllala.
6. Esteriliza los hisopos usados con
desinfectante y descártalos. Pon las cajas en un lugar apartado y déjalas
incubar a la temperatura de 37·C durante 24 a 48 horas. Limpia tu área de
trabajo con la solución desinfectante y lava tus manos.
7.- Repite todo el experimento utilizando
Cajas de cultivo con Agar sangre sólo que ahora selecciona otro Fomite
que no hayas empleado
7. Después de que hayan pasado dos días, mira
las cajas de Petri iniciales. No la abras. A la vez examina las otras cajas de
Petri sin abrirlas. Crea una tabla que compare las cajas sembradas antes y
después de limpiar el objeto (mira la tabla de ejemplo). Asegúrate de indicar
si los microbios crecieron en cada siembra.
8. Nota: Cuidadosamente abre las cajas
de Petri en un lavaplatos e inúndalas con blanqueador o alcohol sin diluir.
Déjalas por una hora y enjuágalas completamente; colócalas en una bolsa
plástica, amárrala y descártala. Asegúrate de no tocar la superficie de las
cajas cuando las abras y lava tus manos cuidadosamente después de manipularlas.
Limpia tú área de trabajo con la solución desinfectante.
RESULTADOS:
CUESTIONARIO
1.
Qué
es un cultivo puro de microorganismos?
Un cultivo puro es aquel que contiene
un solo tipo de microorganismo. El modo de obtener estos cultivos consiste en
obtener colonias aisladas, que provienen de una sola célula (son clones).
2.
Qué
es un inóculo?
Un inóculo es la Cantidad o
Número de Gérmenes infectantes que son introducidos accidental o
voluntariamente en los tejidos vivos o en medios de cultivos especiales.
3.
Físicamente
en un medio de cultivo de microorganismos cuando se dice que no forma un
cultivo puro?
Se dice que
no forma un cultivo puro aquel cultivo que se obtiene de colonias que
provienen de dos o tres células o contienen diferentes tipos de
microorganismos.
4 Qué
tipo de técnica empleaste para la siembra de microorganismos?
La técnica que se utilizo para la siembre de
los microorganismo es el cultivo por siembre en cajas.
5.
¿En cuál caja crecieron más y más
grandes las colonias? ¿Por qué piensas eso?
En la primera caja fue donde crecieron mas las
colonias porque en la primera caja el cuando se tomo la muestra no se le había
echado ni agua ni desinfectante.
6.
¿Cómo es el patrón que
observas en el tamaño y cantidad de
colonias en cada caja?
El patrón que se observo en cada caja, el
tamaño, cantidad y sus colonias iban disminuyendo
7.
¿Cómo podemos controlar la
contaminación microbiana?
La contaminación microbiana se puede controlar
siendo mas cuidadosos cuando se va a hacer la muestra. Abrir las cajas solo
cuando es necesario, lavarse las manos, conservar un ambiente limpio.
8.
Completa en la siguiente tabla
anotando X en los espacios
correspondientes a las divisiones realizadas en donde hayan crecido los
microorganismos
A) MEDIOS DE CULTIVO CON AGAR
NUTRITIVO
Caja 1
|
Caja 2
|
Caja 3
|
||||||||||
Siembra
|
1
|
2
|
3
|
4
|
1
|
2
|
3
|
4
|
1
|
2
|
3
|
4
|
Crecimiento
|
X X X
|
X X X
|
X X X
|
X X X
|
X X X
|
X X
|
X X X
|
X X
|
X X
|
X
|
X
X
|
X
X
|
B)MEDIOS DE CULTIVO CON AGAR SANGRE
Caja 1
|
Caja 2
|
Caja 3
|
||||||||||
Siembra
|
1
|
2
|
3
|
4
|
1
|
2
|
3
|
4
|
1
|
2
|
3
|
4
|
Crecimiento
|
X X X
|
X X
|
X X X
|
X
|
X X
|
X X X
|
X
|
X
|
X X
|
X
|
X X X
|
X
|
CONCLUSIÓN
Durante este laboratorio se pudo observar las
bacterias que nos rodean en todos lados. También podemos observar la diferencia
que hace los productos desinfectantes en las superficies. En este laboratorio
se pudo comprobar la efectividad del desinfectante y la población de
microorganismos que existen alrededor de nosotros.

No hay comentarios.:
Publicar un comentario